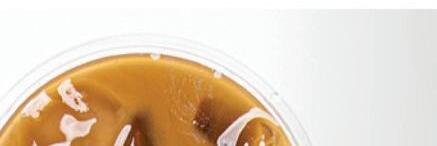

Expires 4/30/21. Mention ad when scheduling quote to apply.

Services





• Individual tax preparation and planning




• Business tax preparation and planning



• Accounting and bookkeeping services, Quick Books training, and payroll services











• Trusts and estate tax preparation





• Contracted controller services









































• Business valuation services
















Member of The Ohio Society of





“We had a problem with Ohio Workers Comp, and Zippay helped us out and saved our business.” — Bruce Peterson, Port Clinton
“Zippay & Co. CPA has been prompt and available for us in our business, and gets it right.” — Sheila Patton, Bowling Green
“ We used to file extensions all the time and never got planning points. Now we’re on time and reduced our audit risks. Zippay & Co. CPA helps us manage our taxes.” — Patricia Eyink, Oak Harbor












































































































